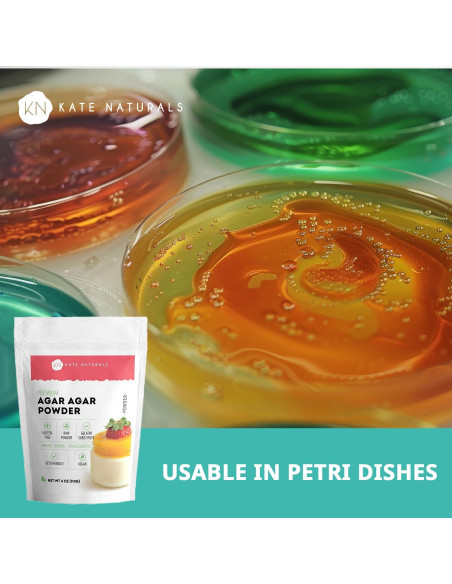
Polvo de Agar Agar Kate Naturals 113.4g - Gelatina Vegana

En Kate Naturals, estamos aquí para apoyar tus necesidades del hogar y rutinas culinarias. Nos dedicamos a proporcionarte productos seguros y de alta calidad para tu hogar y cocina, que van desde polvos alimenticios hasta esenciales para el hogar. El Agar Agar proviene de un tipo de alga roja asiática. Se ha utilizado durante generaciones como una alternativa a la gelatina de origen animal. El Agar Agar se utiliza a menudo en recetas a base de plantas como un espesante natural y alternativa a la gelatina. Es una opción popular para aquellos que siguen estilos de vida veganos o bajos en calorías y una fuente de fibra a base de plantas que se utiliza a menudo en recetas por su textura y versatilidad. Este polvo altamente versátil, no modificado genéticamente, libre de gluten, se puede utilizar como un agente espesante en una serie de recetas veganas y aptas para Keto. Úsalo como un sustituto de gelatina en gelatinas, mermeladas y postres como ositos de goma y helados. El Agar Agar es perfecto para hacer queso vegano ya que su textura firme imita la textura y consistencia de los quesos lácteos tradicionales. Algunos usuarios de bricolaje incorporan Agar Agar en mascarillas faciales caseras por su consistencia similar a un gel. 2 latas de 400g de leche de coco 3 cucharadas de azúcar 1 cucharada de polvo de agar agar 1 vaina de vainilla Tu elección de coberturas 2 cucharaditas de polvo de agar agar 360ml de sidra de manzana espumosa 1 pinta de fresas, cortadas en cuartos 480ml de café 2 cucharaditas de polvo de agar agar 2 cucharadas de azúcar 240ml de jugo de fruta 5 gramos de polvo de agar agar 1 cucharada de miel 240ml de agua Polvo de Agar Agar Lecitina de Girasol en Polvo Goma Xantana Polvo de Fresa
Características destacadas
- POLVO DE AGAR AGAR PARA CARAMELO CRISTAL, GOMITAS, GELATINA Y JELLO: El Polvo de Agar de Kate Naturals (polvo kanten) es un gran sustituto para el polvo de gelatina sin sabor para hacer hojas de gelatina, queso vegano y aquafaba; como agente gelificante alimentario, el polvo de agaragar refuerza y estabiliza postres como goma de agar y se puede utilizar para platos vegetarianos; el polvo de agar se utiliza para hacer delicioso kohakutou (caramelo cristal japonés)
- AGAR AGAR PARA PLACAS DE PETRI: El polvo de agar-agar se puede utilizar para preparar placas de petri para experimentos científicos y proyectos educativos; solo mezcla con agua y déjalo reposar para crear una superficie similar a un gel comúnmente utilizada en aulas y laboratorios
- AGAR AGAR PARA GELATINA DE VINO Y HORNEADO: El Polvo de Agar-Agar se utiliza para hacer gelatina de vino, mezcla de jello vegano, hornear pasteles, cupcakes y postres; esta alternativa de gelatina a base de plantas también se puede utilizar para hacer queso a base de plantas
- VEGANO, SIN GLUTEN Y APTA PARA KETO: Nuestro polvo de agar agar de grado alimenticio natural es no modificado genéticamente, kosher, halal, vegano, apto para keto y sin gluten; dado que el agaragar se deriva de algas, es un gran sustituto de polvo de gelatina vegana y vegetariana; este agente espesante funciona tan bien como las escamas de agar agar y se puede utilizar para hacer una serie de deliciosas recetas keto, halal y veganas
- POLVO DE AGAR DE ALTA CALIDAD: Nuestro objetivo es ofrecer el polvo de agar agar para cocinar de la más alta calidad; si no te gusta, háznoslo saber para que podamos solucionarlo
Modelo de esta publicación
- Tamaño: 113.4 gramos (Paquete de 1)
Especificaciones técnicas
- Tamaño: 113.4 gramos (Paquete de 1)
- Unidades: 113.4 gramos
- Fabricante: Kate Naturals
- Número de modelo del artículo: 4135
- Peso: 0.2 kg
- Dimensiones: Ancho: 20.32 cm, Alto: 12.7 cm, Profundidad: 6.35 cm